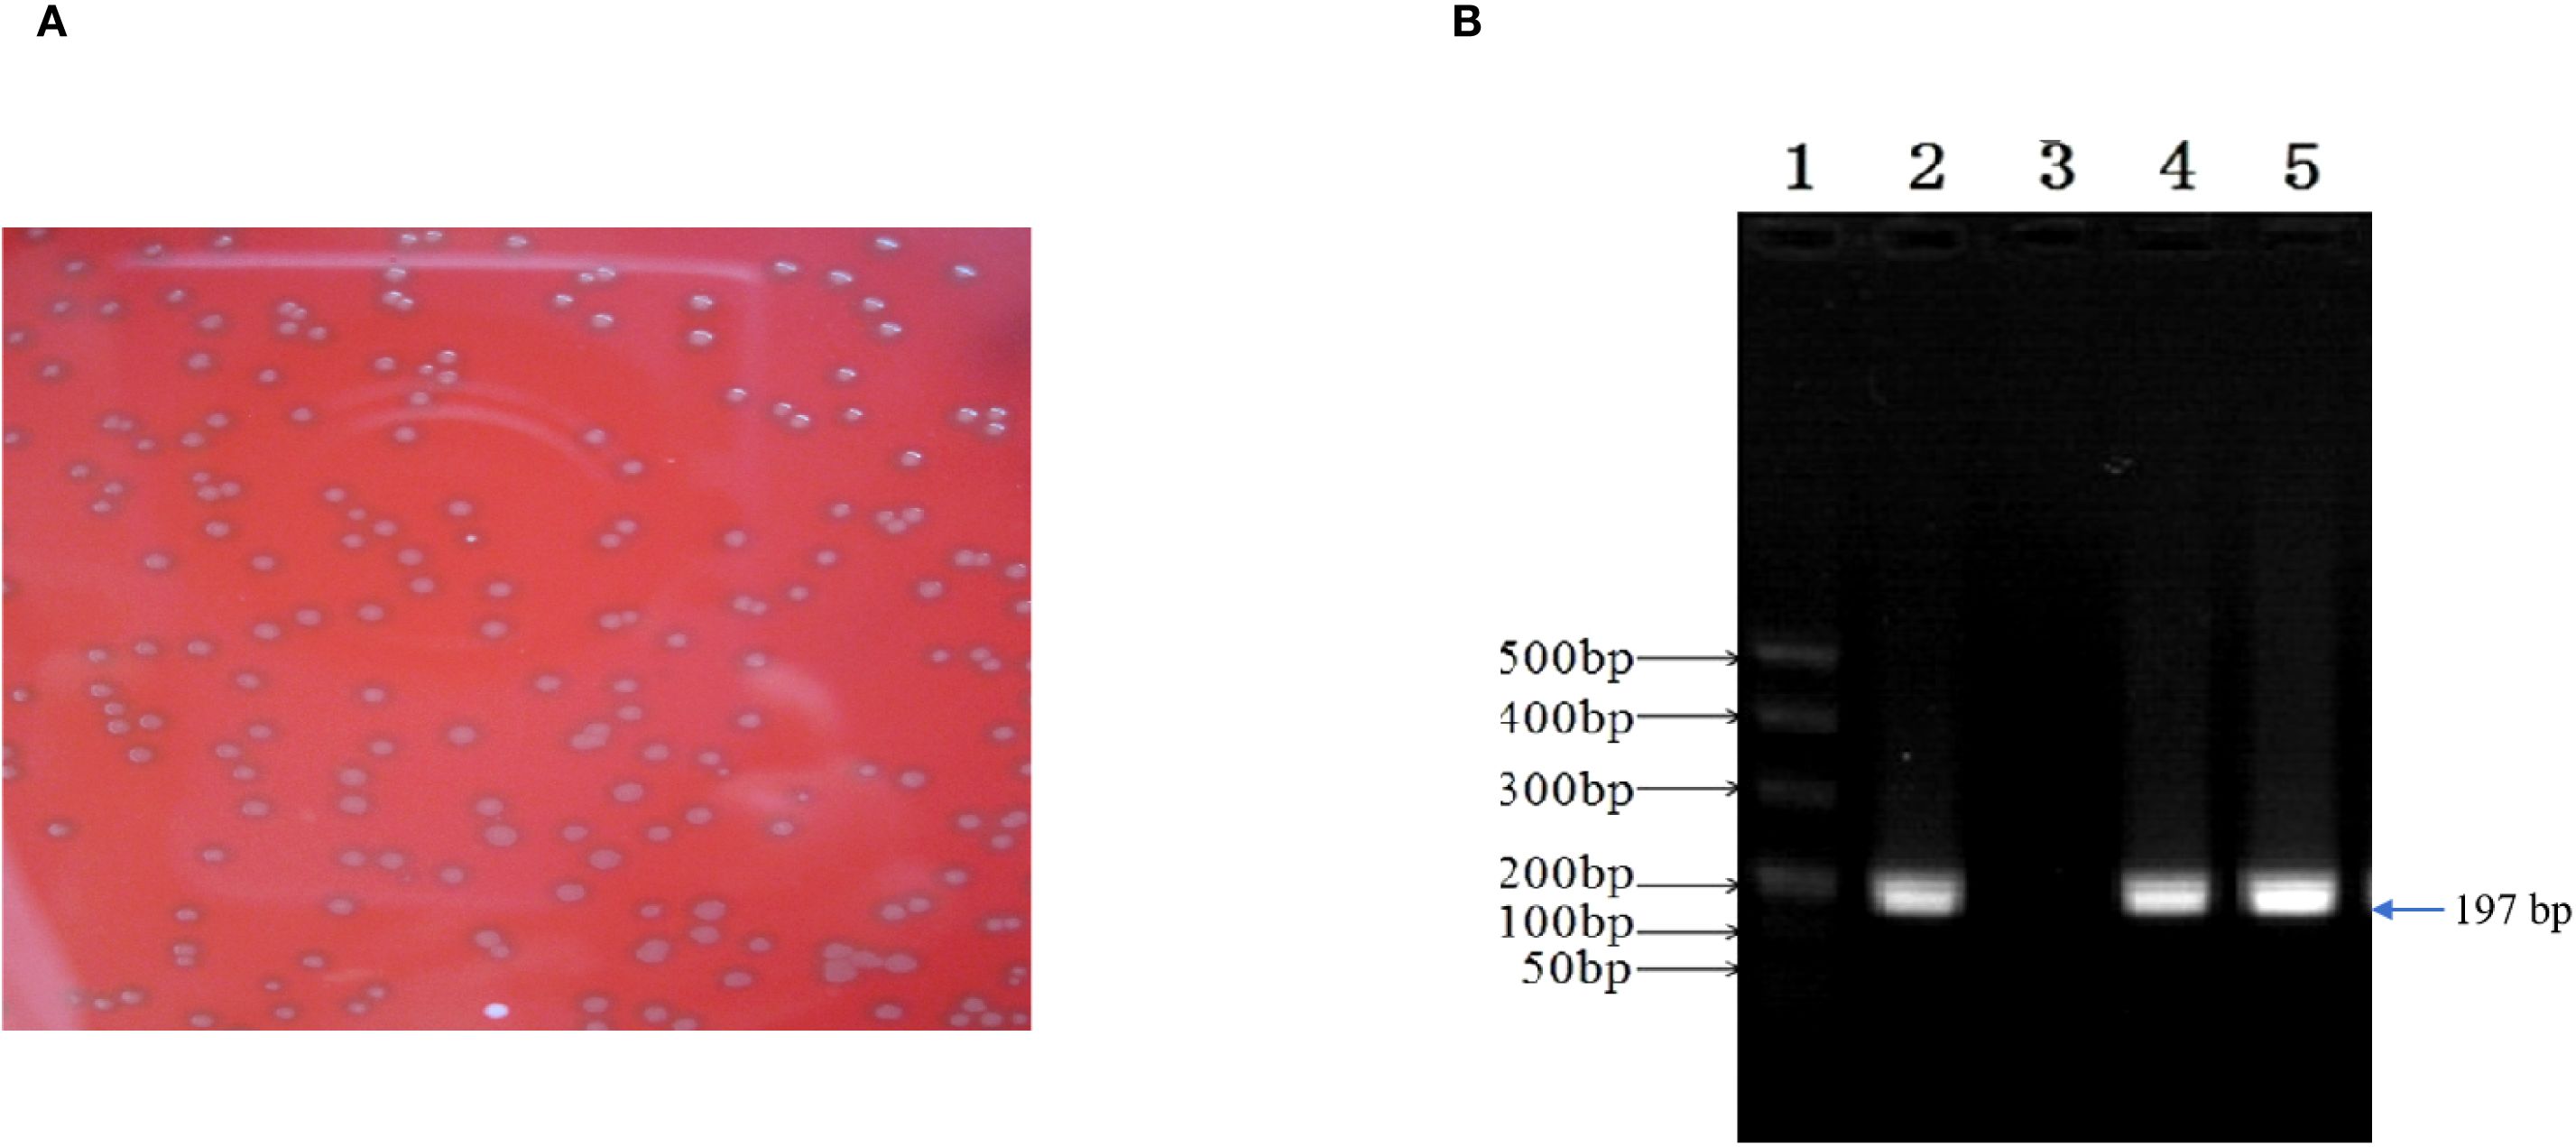

- 1National Key Laboratory of Veterinary Public Healthy Security, College of Veterinary Medicine, China Agricultural University, Beijing, China
- 2Department of Critical Care Medicine, The Second People’s Hospital, Changde, Hunan, China
- 3Reproductive Medicine Centre, Department of Obstetrics and Gynecology, The Second Xiangya Hospital, Central South University, Changsha, Hunan, China
Background: This study aimed to isolate and identify Chlamydia psittaci (C. psittaci) and Enterococcus faecalis (E. faecalis) from a patient suspected of community-acquired pneumonia.
Methods: The samples from the patient (lung lavage and throat swab) and his son (throat swab) were tested to determine antibodies against COVID-19 and C. psittaci-specific IgG. Afterward, 40 female mice were inoculated intranasally with coinfection of C. psittaci and E. faecalis and primary infection of C. psittaci followed by E. faecalis. Meanwhile, eight mice with C. psittaci and E. faecalis infection alone served as the control group. Clinical signs, lung lesions, and pathogen loads were monitored.
Results: Positive C. psittaci genomics were detected in both the patient’s lung lavage and his son’s swabs, while C. psittaci and E. faecalis were isolated and identified from the patient’s lung lavage samples. Moreover, positive C. psittaci-specific IgG and negative COVID-19 antibodies were determined. The patient recovered after 10-day doxycycline treatment. Mice showed weight loss, breathing difficulties, and diffuse alveolar damage after inoculation with C. psittaci followed by E. faecalis.
Conclusion: Our experiment demonstrated that coinfection, particularly sequential infection with C. psittaci followed by E. faecalis, can duplicate severe respiratory distress and typical pathological lesions.
1 Introduction
Since December 8, 2019, several cases of unknown respiratory disease have been reported in Wuhan, Hubei Province, China. Subsequently, Changde, Beijing, Shanghai, Japan, and Korea reported severe febrile respiratory illness that spread to household members and healthcare workers (Ciotti et al., 2019; Islam et al., 2022). Clinically, it was difficult to differentiate between novel coronavirus and Chlamydia psittaci infection, with similar symptoms including high fever, sore throat, and dry cough (Cianfarani, 2019; Jin et al., 2021). Moreover, C. psittaci infection is similar to other types of community-acquired pneumonia, including Chlamydia pneumoniae, Legionella pneumophila, Mycoplasma pneumoniae, and human metapneumovirus (Qin et al., 2022; Liu et al., 2023). In 2020, four medical workers were diagnosed with C. psittaci pneumonia during routine COVID-19 screening in the Second Xiangya Hospital, Hunan, China (Lei et al., 2021).
A 50-year-old farmer who was a patient at the time also experienced severe breathing difficulties with a high fever. The patient had an initial medical history of heart disease and diabetes for up to 7 years. Following his sickness, he was admitted to the Second People’s Hospital of Changde, Hunan, China, on December 13, 2019, and was suspected of having avian influenza, as he was raising 50 yellow-feather broilers in his backyard. After hospital admission, he received antivirals for 5 days, and his high fever persisted for an additional week with respiratory distress, including headache, asthma, and chest pains. Five days later, qPCR revealed that he was negative for avian influenza virus and COVID-19. However, positive C. psittaci was detected in lung lavage samples using qPCR assay and whole-genome sequencing. Based on the diagnosis, the sick farmer and his son received 10 mg/kg of doxycycline via injection for 10 days and recovered in the hospital. The patient, his son, and his spouse had positive C. psittaci-specific IgG antibodies after hospitalization. Meanwhile, C. psittaci and Enterococcus faecalis were isolated and identified from the patient’s lung lavage samples.
C. psittaci is an important zoonotic agent with a wide host spectrum, and it causes systemic infection. Its unique biphasic developmental cycle and persistent state assist in the survival and immune escape of host cells. Acute pneumonia (psittacosis) caused by C. psittaci infection is frequently misdiagnosed and poses significant challenges in treatment (Wang et al., 2024). Infected hosts (both animal and human) show a diversity of clinical signs, from asymptomatic disease for a large portion of infected organisms to multiple organ failure, sepsis, and death. In 2018, 13 workers were reported to be infected in a U.S. poultry slaughterhouse, indicating a high risk of zoonotic transmission of psittacosis (Shaw et al., 2019). In recent years, human psittacosis has increased gradually due to the commercial application of whole-genome sequencing and increasing patient survival after therapy (Wu et al., 2021). In December 2020, six employees from a duck meat processing plant and two unemployed people were diagnosed with community-acquired pneumonia and tested positive for C. psittaci using nested PCR and qPCR, indicating human-to-human transmission of C. psittaci in China and an emergent risk (Zhao et al., 2021; Zhang et al., 2022).
However, the pathogenesis between prolonged severe respiratory distress and coinfection of C. psittaci and E. faecalis is unknown. The purpose of this study was to illustrate the potential contribution of a combination of C. psittaci and E. faecalis in driving critical respiratory distress.
2 Materials and methods
2.1 Temperature curve and clinical samples
A patient with community-acquired pneumonia was admitted to a designated hospital in Changde, Hunan, China, on December 13, 2019, and an alert was triggered twice due to two waves of high fever on December 20 and December 25–30, 2019. One week later, while caring for his father, the patient’s 30-year-old son also had a high fever. After treatment with doxycycline for 11 days, both his high fever and breathing difficulty were under control (Supplementary Figure S1). Finally, he was discharged from the local hospital before the COVID-19 outbreak in Wuhan, approximately 260 km away from his hometown. During his hospital admission, samples were collected with his family’s consent (Supplementary Table S1). Moreover, swabs, sera, and an alveolar wash were collected from his relatives and close contacts (Supplementary Table S2). Before collecting any clinical samples, signed informed consent was sought from possible participants, including family members, the attending physician, and the nurses. Also, the study was approved by the institutional review board (IRB) of China Agricultural University. The collected throat swabs were kept in sucrose-phosphate-glutamate (SPG) solution at 4°C, while the sera were stored at −20°C for further testing.
2.2 COVID-19 and Chlamydia tests
All serum samples were detected using a commercial antibody kit (Lizhu Biotech Co., Ltd., Shenzhen, China), and RNA samples were analyzed in accordance with the qPCR protocol recommended by the WHO (Corman et al., 2020) using COVID-19 primers (Supplementary Table S3).
Genomic sequences were amplified for Chlamydia tests using specific primers (Table 1). The Chlamydia genus was determined using the following: 2× super mix 12.5 µL, 10 µM Chlamydia forward primer 1.5 µL, 10 µM reverse primer 1.5 µL, and 0.5–1 µg DNA. The PCR conditions were conducted as follows: 95°C, 5 min, denaturing at 95°C for 30 s, annealing at 56°C for 30 s, and extending at 72°C for 30 s. The cycle was repeated 30 times, and the final reaction was incubated at 72°C for 10 min. Whole-genome sequencing was performed by a commercial institute (Beijing Genomics Institution, BGI, Beijing, China). For C. psittaci detection, the ompA gene was determined using qPCR (Applied Biosystems™ 7500, Thermo Fisher, Beijing, China) as described previously (Fang et al., 2021). The qPCR reagents included 5 µL SYBR Reaction Mix (2×) (TransGen Biotech, Beijing, China), 1 µL forward primer (2.5 μM), 1 µL reverse primer (2.5 μM), 1 µL template DNA, and 2 µL ddH2O. qPCR was performed as follows: 50°C for 10 min, 95°C for 5 min, 95°C for 10 s, 60°C for 30 s, 45 cycles of 95°C for 1 min, 55°C for 1 min, and 55°C–95°C (0.5°C increment) for 10 s. The ompA gene of C. psittaci, approximately 1,209 bp, was amplified as described previously (Fang et al., 2021). It was subjected to electrophoresis in a 1% (w/v) agarose gel. The PCR product was sequenced by a commercial company (Tsingke Biotechnology Co., Ltd., Beijing, China).
The throat swabs collected from the patient and his relatives were mixed in 900 μL phosphate buffered saline (PBS) containing 2,000 IU/mL gentamicin and 2,000 IU/mL streptomycin (Solarbio Science & Technology Co., Ltd., Beijing, China). After incubation for 30 min at 37°C and centrifugation at 500 × g for 5 min at 4°C, the supernatant (0.4 mL) was collected and injected into 7-day-old specific pathogen free (SPF) embryonated chicken eggs at 0.2 mL per egg. Afterward, the embryonated chicken eggs were incubated at 37°C for 1 week, and the embryonated chicken eggs were monitored twice per day. The second passage was carried out to observe the pathogenicity using the yolk membranes (Zhang et al., 2009). The typical inclusion bodies were monitored using the IMAGEN™ Chlamydia kit (Thermo Scientific, Beijing, China), and specific species of C. psittaci was verified using the aforementioned qPCR. For antibody detection, C. psittaci-specific human antibodies were detected using SeroFIA™ C. psittaci immunofluorescence detection assay (Savyon Diagnostics Ltd., Ashdod, Israel) following the manufacturer’s instructions (Ling et al., 2015).
2.3 Identification and propagation of E. faecalis
DNA samples were extracted from the positive E. faecalis isolates using the DNeasy Tissue Kit (Qiagen, Hilden, Germany) following the manufacturer’s instructions. The following specific primers were used in the study. The forward primer was 5′-GTACAGTTGCTTCAGGACGTATC-3′, and the reverse primer was 5′-ACGTTCGATTTCATCACGTTG-3′. A 197-bp fragment of the tuf gene was amplified and subjected to electrophoresis in a 1% (w/v) agarose gel. The PCR procedure comprised an initial incubation for 4 min at 95°C, 35 cycles for 60 s each at 95°C, annealing for 60 s at 59°C, and extension for 60 s at 72°C, with a final extension for 5 min at 72°C (Pan et al., 2012). The PCR product was sequenced, and then NCBI blast was used.
All throat swabs were grown on standard I nutrient agar (Merck, Darmstadt, Germany) with 5% sheep blood and incubated at 37°C for 24 h. The positive colonies were transferred into the Baird–Parker medium (Qingdao Hope Bio-Technology Co., Ltd., Shandong, China). Afterward, the typical colonies were identified using Gram staining and biochemical assays (Sigma-Aldrich, Beijing, China). The biochemical tests assayed for glucose, fructose, sucrose, maltose, lactose, galactose, mannose, mannitol, sorbitol, arabinose, inulin, urease, lysine decarboxylase, nitrate, gelatinase, motility, indole, 0.1% methylene blue milk, and growth on MacConkey agar in bouillon medium at pH 9.6, sodium hippurate medium, and 6.5% NaCl bouillon medium. Bacterial colony forming unit (CFU) was quantified on nutrient agar containing 5% sheep blood (Pan et al., 2012).
2.4 Mice inoculated with C. psittaci and E. faecalis
The animal test was designed in accordance with guidelines issued by the Institutional Animal Care and Use Committee (IACUC) and followed humane protocols to minimize animal pain. It was approved by the Ethics Review Committee of China Agricultural University (approval code: IACUC20191222). Forty C57BL/6 mice weighing 20–22 g were randomly assigned to five groups with eight animals per group (Supplementary Table S4) and maintained in negative isolators in biosafety level 2 facilities. In the current study, Group 1 mice were infected intranasally with 0.1 mL of 1.0 × 105 inclusion forming unit (IFU) of C. psittaci isolate alone. Group 2 mice were inoculated intranasally with 0.1 mL of 1.0 × 107 CFU of E. faecalis isolate alone. Group 3 mice received intranasally 1.0 × 107 CFU of E. faecalis and 0.1 mL of 1.0 × 105 IFU of C. psittaci at the same time. Group 4 mice were first inoculated intranasally with 1.0 × 105 IFU of C. psittaci isolate and then inoculated with 0.1 mL of 1.0 × 107 CFU of E. faecalis through the same route after 3 days. This infection model was used to identify whether primary C. psittaci infection would aggravate E. faecalis-mediated respiratory distress. Group 5 mice received sterile 0.1 mL of PBS via the same route, serving as the healthy control. Mouse body weights were monitored weekly until the end of the experiment. After 14 days, the mice were anesthetized by intraperitoneal injection into the right lower quadrant of the abdomen with 2 mg ketamine and 0.2 mg xylazine (Jianglei Biotech Co., Ltd., Shanghai, China).
2.5 Evaluation of lung pathological lesions
Lungs were harvested from each group of euthanized mice, examined for pathological lesions, and scored. Lung lesions were determined according to a previous description (Li et al., 2022). Briefly, for lungs, the grades were as follows: grade 0, lines normal; grade 1, 30% of the lung surface area showed hemorrhage, degeneration, or necrosis; grade 2, 60% of the lung surface area showed hemorrhage, degeneration, or necrosis; and grade 3, the entire lung surface showed hemorrhage, degeneration, or necrosis. For lung sections, the grades were as follows: grade 0, none; grade 1, slight edema of the alveolar walls; grade 2, moderate edematous thickening of alveolar walls with occasional alveoli containing coagulated edema fluid; and grade 3, extensive occurrence of alveolar and interstitial edema.
2.6 Pathogen loads
The mouse lungs were aseptically removed on day 14. Briefly, sterile lung tissues of eight mice from each group were taken and then minced, and 50 mg of lung tissues from each mouse and supernatant lung homogenates were obtained. The homogenates were stored at 4°C for 40 min and then centrifuged at 2,000 rpm/min for 5 min. The supernatant was used to determine the concentration of C. psittaci by qPCR (Fang et al., 2021). For E. faecalis determination, the samples from the lungs were inoculated on standard I nutrient agar (Merck, Germany) with 5% sheep blood and incubated at 37°C for 24–48 h. Finally, the number of bacterial colonies was measured.
2.7 Statistical analysis
Statistical significance was analyzed using one-way ANOVA with the least significant difference (LSD) post-hoc test. Data were expressed as the mean ± standard deviation. All data were calculated and analyzed using SPSS v26.0 (SPSS Inc., Chicago, IL, USA). Graphs were generated using the GraphPad Prism 9 software (GraphPad Software, San Diego, CA, USA). Statistically significant differences were judged as p < 0.05.
3 Results
3.1 Detection of C. psittaci and specific antibodies from the patient and his close contacts
After the patient’s hospital admission, his chest X-ray revealed bilateral pneumonia and ground-glass opacity, and he was prescribed oxygen therapy and doxycycline. Afterward, lesions with ground-glass opacity were reduced, but pulmonary consolidation was still observed in the lungs (Supplementary Figure S2). Based on 23S rDNA amplification, a positive 172-bp band of C. psittaci was detected in the patient’s alveolar wash, while his tracheal mucosa and throat swabs were negative (Figure 1A). Other family members, the nurses, the attending physician, and the house chickens were negative for C. psittaci (Figure 1B). Afterward, qPCR results showed that the patient’s alveolar wash was positive for C. psittaci. Subsequently, positive C. psittaci was identified in the patient’s alveolar wash and throat swab, and his sons’ throat swab. However, a negative reaction was found in his tracheal mucosa and other close contacts’ samples (Figure 2). The ompA gene sequence of the C. psittaci strain was determined and submitted to GenBank (accession number: OR616243). After inoculation into SPF embryonated eggs, typical intracellular inclusions were observed using immunofluorescence staining (Figure 3).

Figure 1. Detection of Chlamydia psittaci from patient’s samples and his close contacts using 23S rDNA PCR. (A) Positive C. psittaci was detected in the patient’s alveolar lavage (M, marker; 1, alveolar lavage; 2, throat swabs; 3, tracheal mucosa; 4, C. psittaci 6BC control; 5, negative control). (B) Negative samples of patient’s close contacts (M, marker; 1–7, patient’s relatives; 8, doctor; 9, nurse; C1–C10, chicken samples; N, negative control; P, positive control).

Figure 2. Detection of Chlamydia psittaci using qPCR assay. (A) Positive C. psittaci was detected in patient’s alveolar lavage and throat swab, while negative reaction was detected in tracheal mucosa. A, B: Tracheal mucosa, C, D: throat swabs, E, F: alveolar lavage, and G, H: C. psittaci. (B) Positive reaction was identified in his son’s throat swabs (D), and negative reaction was identified in his close contact’s samples: tracheal mucosa (A–C, E–H).

Figure 3. Positive Chlamydia psittaci strain was isolated from patient’s throat swab samples using immunofluorescence staining. Blue, 4',6-diamidino-2-phenylindole (DAPI)-stained host cells. Green, fluorescein isothiocyanate (FITC)-labeled lipopolysaccharide (LPS) antibody against Chlamydia.
For C. psittaci-specific antibodies, IgG antibody titers were arranged from 1:64 dilution on December 25 and increased to 1:128 dilution on December 27, 2019, in a time-course manner (Figure 4). Compared to the patient’s sera, IgG titers were from 1:32 to 1:64 to 1:128, and the serum samples from other close contacts were negative in the test. Meanwhile, antibodies against COVID-19 were negative (Table 2). Serum samples from the patient were also tested for antibodies against common respiratory pathogens, including influenza A/B virus, respiratory syncytial virus, C. pneumoniae, and M. pneumoniae. All results were negative.

Figure 4. Specific antibodies against Chlamydia psittaci during patient’s hospital admission. (A) Positive antibody to C. psittaci was observed on December 25, 2019. (B) Highly intensive C. psittaci-specific antibodies were observed in a time-course manner on December 27, 2019.

Table 2. Detection of Chlamydia psittaci-specific IgG and COVID-19 antibodies in the sera of the patient and his close contacts.
3.2 Isolation and characterization of E. faecalis
E. faecalis was successfully isolated in the alveolar lavage and throat swab using single-colony purification. Subsequently, the isolate was classified using biochemical assays and conventional PCR, and E. faecalis isolates were found to be Gram-positive, chain-forming, coccus-shaped organisms upon microscopic inspection (Figure 5A). The isolated strains were determined as E. faecalis using PCR. The DNA extracted from the typical colony produced the expected 197-bp PCR product of the target gene (Figure 5B); the sequence of the tuf gene was submitted to GenBank (accession number: SUB15618628), and NCBI blast was used. A sequence analysis of the tuf segment showed that the sequence from this isolate was 98%–100% homologous to the E. faecalis reference strains (GenBank # EU156939 and AY266992).
Figure 5. Enterococcus faecalis was isolated and identified from patient’s alveolar lavage and throat swabs. (A) Typical colonies of E. faecalis grew on Columbia Blood Agar Base Medium. (B) The isolate generated 197-bp PCR product. 1, marker; 2, positive control; 3, negative control; 4, patient’s alveolar lavage; 5, patient’s throat swab.
3.3 Pathogenicity of coinfection with C. psittaci and E. faecalis
Clinically, mice infected primarily with C. psittaci, followed by E. faecalis (C. psittaci/E. faecalis) inoculation or C. psittaci infection alone, showed ruffled feathers, inactivity, poor appetite, and low weight; especially severe signs were found in female mice compared to male mice. For body weights, those of the C. psittaci/E. faecalis group, C. psittaci alone group, and C. psittaci+E. faecalis group were lower 1 week later. More importantly, mouse body weights declined during the observation in the C. psittaci/E. faecalis group (p < 0.01). However, no decrease was found in the E. faecalis alone group and the control group (Figure 6).

Figure 6. Body weight after inoculation with coinfection with Chlamydia psittaci or Enterococcus faecalis in mice. Two weeks post-infection, the body weight levels of the C. psittaci/E. faecalis group were lower than those of the other three groups (p < 0.01). No statistical difference was found in the E. faecalis alone group and the control group. The differences were analyzed using ANOVA (p < 0.05, p < 0.01).
Postmortem, diffuse hemorrhagic lungs were observed in the mice with C. psittaci infection alone, while enlarged lung size was evident in the mice with E. faecalis infection (Figure 7). For C. psittaci/E. faecalis group and the C. psittaci+E. faecalis group, atrophy, viscous exudation, and diffuse hemorrhage characterized severe lesions, while fibrinous consolidation developed in the C. psittaci+E. faecalis group (Figure 7D).

Figure 7. Lung lesions after coinfection with Chlamydia psittaci and Enterococcus faecalis in mice. (A) Control group, (B) C. psittaci alone group, (C) E. faecalis alone group, (D) C. psittaci+E. faecalis group, and (E) C. psittaci/E. faecalis group.
Under microscopic observation, severe consolidation lesions were observed in the C. psittaci+E. faecalis group and C. psittaci/E. faecalis group, diffuse hemorrhagic inflammation was evident in the lungs of the C. psittaci alone group, and no obvious lesions were found in the E. faecalis alone group (Figure 8).

Figure 8. Lung lesions after coinfection with Chlamydia psittaci and Enterococcus faecalis in mice under microscopic observation. (A) Control group, (B) C. psittaci alone group, (C) E. faecalis alone group, (D) C. psittaci+E. faecalis group, and (E) C. psittaci/E. faecalis group.
Regarding bacterial loads, high chlamydial loads were determined in the C. psittaci/E. faecalis group compared to the C. psittaci+E. faecalis group or C. psittaci alone group (p < 0.05) (Figure 9A). On the contrary, no significant difference in E. faecalis clearance was found between the C. psittaci/E. faecalis group and the C. psittaci+E. faecalis group (Figure 9b).

Figure 9. Determination of bacterial loads in the mouse lungs after coinfection with Chlamydia psittaci or Enterococcus faecalis. (A) C. psittaci loads in lungs on day 14 post-challenge. The symbol * indicates a statistically significant difference (p < 0.05). (B) E. faecalis loads in lungs on day 14 post-challenge. No significant difference in E. faecalis clearance was found between the C. psittaci/E. faecalis group and the C. psittaci+E. faecalis group (B). The differences were analyzed using ANOVA (p < 0.05, p < 0.01).
4 Discussion
In the present study, positive genomics, C. psittaci isolate, and seropositive sera were determined in the patient’s samples, and E. faecalis was also recovered from his alveolar lavage and throat swabs. After therapy with doxycycline for 11 days, both high fever and respiratory distress were alleviated gradually, and the patient survived before the COVID-19 outbreak and quarantine in Wuhan. In the evidence-based animal study, both C. psittaci+E. faecalis and C. psittaci/E. faecalis infections aggravated mouse respiratory distress, characterized as diffuse hemorrhage, exudation, and fibrinous consolidation in mouse lungs, which were consistent with the white-like lungs of the patient after hospital admission. Therefore, primary infection with C. psittaci and secondary infection with E. faecalis may be associated with the patient’s respiratory distress.
Naturally, human C. psittaci infection is a typical zoonosis transmitted via inhalation of aerosolized particles from infected birds (Wang et al., 2024). The clinical manifestations range from asymptomatic illness to life-threatening pneumonia. E. faecalis, as a common commensal bacterium in the human gastrointestinal tract, is an opportunistic pathogen. It most often causes endogenous infections, such as urinary tract infections and bacteremia, when host immunity is compromised. One report implied that E. faecalis could cause pneumonia and lung abscesses in immunocompromised individuals (Mendes et al., 2020). However, coinfection of C. psittaci and E. faecalis remains elusive.
In our study, both C. psittaci and E. faecalis were identified in the patient with high fever. However, the definitive contribution of each pathogen to the severe pneumonia remained elusive. To our knowledge, human psittacosis can manifest as an asymptomatic syndrome with silent infection. Some employees from duck meat plants were reported to present flu-like symptoms or pneumonia after C. psittaci infection and recovered without treatment (Zhang et al., 2022). Severe symptoms in the patient may be associated with immunosuppression due to the presence of heart disease and type 2 diabetes for up to 7 years. The simultaneous onset of type 2 diabetes mellitus and heart disease significantly reduces the body’s immune response (Yap et al., 2019). The patient’s chronic disease may have contributed to his two-time high fever in the hospital. Recent analysis showed that immunocompromised patients overall had a 44% higher risk of death in hospital than patients with normal immune systems over the course of the COVID-19 pandemic. However, highly pathogenic C. psittaci infection could induce an immunocompromised state and aggravate H9N2 infection (Chu et al., 2016). In this study, the patient suffered from C. psittaci-elicited immunosuppression and chronic disease with low immunity and was sensitive to viral or bacterial infection. In the mouse model, C. psittaci infection caused hemorrhagic inflammation in the lungs, and a primary infection with C. psittaci followed by E. faecalis inoculation not only caused mice to develop more severe breathing difficulties than C. psittaci infection alone, but also caused a high number of lesions in the lungs of the C. psittaci/E. faecalis group. The above facts confirm our hypothesis that a primary infection with C. psittaci establishes a compromised lung environment that is severely exacerbated by secondary E. faecalis inoculation.
The potential role of E. faecalis is unclear over the patient’s disease course. Enterococci are rarely considered pulmonary pathogens, and they are considered colonizers of the airway. One patient was diagnosed with E. faecalis-associated acute primary lung abscess, highlighting E. faecalis as an etiologic agent in cases of non-resolving or complicated cases of pneumonia (Mendes et al., 2020). Moreover, epidemiological investigation confirmed a correlation between E. faecalis clones isolated from food-producing animals and human urinary tract infections caused by E. faecalis in France in 2016 (Abat et al., 2016). In slaughter animals, E. faecalis from human milk is claimed to be avirulent and antibiotic sensitive and does not breach the gut barrier (Anjum et al., 2022). However, some reports showed that E. faecalis harboring antibiotic resistance genes may contribute to bovine mastitis and act as a reservoir for the transmission of virulence factors to humans (Kim et al., 2022). In the present study, the E. faecalis isolate from the patient and his son may have originated from backyard chickens due to daily feeding activities. After inoculation into mice, hemorrhagic inflammation of the lungs was evident in both the C. psittaci+E. faecalis group and C. psittaci/E. faecalis group, but no typical lesion was found in the lungs infected with E. faecalis alone. Our animal model provided strong evidence that E. faecalis, which originated from animal-based food, may be an opportunistic human pathogen that worsens C. psittaci injury by increasing the burden of C. psittaci in the lungs. Moreover, it may be a real zoonotic pathogen with a potentially highly significant impact on human health.
The initial clinical and radiological presentation of the patient, characterized by high fever, bilateral ground-glass opacities, and hemorrhagic lesions, posed a significant diagnostic challenge, as it closely mimicked severe COVID-19 pneumonia and avian influenza (Zhao et al., 2021). This overlap in features, including the progression to “white lung” in severe cases (Coronaviridae Study Group of the International Committee on Taxonomy of Viruses, 2020; Attaway et al., 2021), underscores the critical importance of differential diagnosis in the context of a pandemic. Notably, the diffuse hemorrhagic inflammation observed in our coinfection mouse model differed from the typical fibrotic consolidation seen in advanced COVID-19 (Yin and Wunderink, 2018), suggesting distinct pathogenic mechanisms. In view of the rapid identification of human psittacosis from community-acquired pneumonia, RT-PCR and metagenomic next-generation sequencing are recommended for clinical diagnosis.
In conclusion, positive C. psittaci genomics and seroprevalence were identified in the patient. Subsequently, both C. psittaci and E. faecalis were isolated from the patient’s samples. After treatment with doxycycline, the patient recovered and was discharged from the hospital, suggesting that C. psittaci infection may have aggravated respiratory distress by aggravating his weak immunity. Our experimental data further demonstrate that secondary infection with E. faecalis can exacerbate respiratory distress and produce pathological lesions reminiscent of COVID-19. Various strategies must be urgently implemented to highlight this public health threat, in particular through the development and implementation of large surveillance systems based on animal and human health data to enable us to detect the prevalence of C. psittaci and E. faecalis.
Data availability statement
The datasets presented in this study can be found in online repositories. The names of the repository/repositories and accession number(s) can be found in the article/Supplementary Material.
Ethics statement
The studies involving humans were approved by Human Ethical Committee of China Agricultural University (Beijing, China). The studies were conducted in accordance with the local legislation and institutional requirements. The participants provided their written informed consent to participate in this study. The animal study was approved by Laboratory Animal Ethical Committee of China Agricultural University (Beijing, China). The study was conducted in accordance with the local legislation and institutional requirements.
Author contributions
XZ: Writing – original draft, Formal Analysis. YiW: Writing – original draft, Conceptualization, Methodology. YuW: Data curation, Writing – original draft. YC: Writing – original draft, Software. HW: Writing – original draft, Formal Analysis. ZH: Writing – original draft, Investigation. LL: Conceptualization, Writing – original draft. LT: Writing – original draft, Investigation. JC: Writing – original draft, Supervision. CH: Methodology, Conceptualization, Supervision, Writing – review & editing, Funding acquisition.
Funding
The author(s) declare financial support was received for the research and/or publication of this article. This work was supported by the Ministry of Science and Technology of China (Grant No. 2022YFC2304000).
Acknowledgments
We want to express our gratitude to everyone who offered advice and help in this work.
Conflict of interest
The authors declare that the research was conducted in the absence of any commercial or financial relationships that could be construed as a potential conflict of interest.
Generative AI statement
The author(s) declare that no Generative AI was used in the creation of this manuscript.
Any alternative text (alt text) provided alongside figures in this article has been generated by Frontiers with the support of artificial intelligence and reasonable efforts have been made to ensure accuracy, including review by the authors wherever possible. If you identify any issues, please contact us.
Publisher’s note
All claims expressed in this article are solely those of the authors and do not necessarily represent those of their affiliated organizations, or those of the publisher, the editors and the reviewers. Any product that may be evaluated in this article, or claim that may be made by its manufacturer, is not guaranteed or endorsed by the publisher.
Supplementary material
The Supplementary Material for this article can be found online at: https://www.frontiersin.org/articles/10.3389/fcimb.2025.1662902/full#supplementary-material.
References
Abat, C., Huart, M., Garcia, V., Dubourg, G., and Raoult, D. (2016). Enterococcus faecalis urinary-tract infections: Do they have a zoonotic origin? J. Infect. 73, 305–313. doi: 10.1016/j.jinf.2016.07.012
Anjum, J., Zaidi, A., Barrett, K., and Tariq, M. (2022). A potentially probiotic strain of Enterococcus faecalis from human milk that is avirulent, antibiotic sensitive, and nonbreaching of the gut barrier. Arch. Microbiol. 204, 158. doi: 10.1007/s00203-022-02754-8
Attaway, A. H., Scheraga, R. G., Bhimraj, A., Biehl, M., and Hatipoğlu, U. (2021). Severe COVID-19 pneumonia: pathogenesis and clinical management. Bmj 372, n436. doi: 10.1136/bmj.n436
Chu, J., Zhang, Q., Zhang, T., Han, E., Zhao, P., Khan, A., et al. (2016). Chlamydia psittaci infection increases mortality of avian influenza virus H9N2 by suppressing host immune response. Sci. Rep. 6, 29421. doi: 10.1038/srep29421
Cianfarani, S. (2019). Pediatric endocrinology in the time of the COVID-19 pandemic. Horm. Res. Paediatr. 92, 345–346. doi: 10.1159/000507703
Ciotti, M., Angeletti, S., Minieri, M., Giovannetti, M., Benvenuto, D., Pascarella, S., et al. (2019). COVID-19 outbreak: an overview. Chemotherapy 64, 215–223. doi: 10.1159/000507423
Corman, V. M., Landt, O., Kaiser, M., Molenkamp, R., Meijer, A., Chu, D. K., et al. (2020). Detection of 2019 novel coronavirus (2019-nCoV) by real-time RT-PCR. Euro Surveill 25, 2000045. doi: 10.2807/1560-7917.ES.2020.25.3.2000045
Coronaviridae Study Group of the International Committee on Taxonomy of Viruses (2020). The species Severe acute respiratory syndrome-related coronavirus: classifying 2019-nCoV and naming it SARS-CoV-2. Nat. Microbiol. 5, 536–544. doi: 10.1038/s41564-020-0695-z
Fang, H., Quan, H., Zhang, Y., Li, Q., Wang, Y., Yuan, S., et al. (2021). Co-Infection of Escherichia coli, Enterococcus faecalis and Chlamydia psittaci Contributes to Salpingitis of Laying Layers and Breeder Ducks. Pathogens 10, 755. doi: 10.3390/pathogens10060755
Islam, M. A., Haque, M. A., Rahman, M. A., Hossen, F., Reza, M., Barua, A., et al. (2022). A review on measures to rejuvenate immune system: natural mode of protection against coronavirus infection. Front. Immunol. 13. doi: 10.3389/fimmu.2022.837290
Jin, Y., Hou, C., Li, Y., Zheng, K., and Wang, C. (2021). mRNA vaccine: how to meet the challenge of SARS-coV-2. Front. Immunol. 12. doi: 10.3389/fimmu.2021.821538
Kim, H. J., Youn, H. Y., Kang, H. J., Moon, J. S., Jang, Y. S., Song, K. Y., et al. (2022). Prevalence and Virulence Characteristics of Enterococcus faecalis and Enterococcus faecium in Bovine Mastitis Milk Compared to Bovine Normal Raw Milk in South Korea. Anim. (Basel) 12, 1407. doi: 10.3390/ani12111407
Lei, J. H., Xu, Y., Jiang, Y. F., Shi, Z. H., and Guo, T. (2021). Clustering cases of chlamydia psittaci pneumonia in coronavirus disease 2019 screening ward staff. Clin. Infect. Dis. 73, e3261–e3265. doi: 10.1093/cid/ciaa1681
Li, Q., Chen, S., Yan, Z., Fang, H., Wang, Z., and He, C. (2022). A novel intranasal vaccine with pmpGs + MOMP induces robust protections both in respiratory tract and genital system posting chlamydia psittaci infection. Front. Vet. Sci. 9. doi: 10.3389/fvets.2022.855447
Ling, Y., Chen, H., Chen, X., Yang, X., Yang, J., Bavoil, P. M., et al. (2015). Epidemiology of chlamydia psittaci infection in racing pigeons and pigeon fanciers in beijing, China. Zoonoses Public Health 62, 401–406. doi: 10.1111/zph.12161
Liu, Y. N., Zhang, Y. F., Xu, Q., Qiu, Y., Lu, Q. B., Wang, T., et al. (2023). Infection and co-infection patterns of community-acquired pneumonia in patients of different ages in China from 2009 to 2020: A national surveillance study. Lancet Microbe 4, e330–e339. doi: 10.1016/s2666-5247(23)00031-9
Mendes, A. R., Costa, A., Ferreira, H., and Ferreira, C. (2020). Enterococcus faecalis-associated lung abscess in a male adolescent- a case report. BMC Pediatr. 20, 98. doi: 10.1186/s12887-020-2003-8
Pan, Q., Liu, A., and He, C. (2012). Co-infection of Ornithobacterium rhinotracheale with Streptococcus zooepidemicus in chickens. Avian Dis. 56, 680–684. doi: 10.1637/10109-030112-Reg.1
Qin, X. C., Huang, J., Yang, Z., Sun, X., Wang, W., Gong, E., et al. (2022). Severe Community-acquired Pneumonia caused by Chlamydia psittaci Genotype E/B Strain Circulating Among Geese in Lishui City, Zhejiang Province, China. Emerg. Microbes Infect. 11, 2715–2723. doi: 10.1080/22221751.2022.2140606
Shaw, K. A., Szablewski, C. M., Kellner, S., Kornegay, L., Bair, P., Brennan, S., et al. (2019). Psittacosis Outbreak among Workers at Chicken Slaughter Plants, Virginia and Georgia, US. Emerg. Infect. Dis. 25, 2143–2145. doi: 10.3201/eid2511.190703
Wang, J., Wang, B., Xiao, J., Chen, Y., and Wang, C. (2024). Chlamydia psittaci: A zoonotic pathogen causing avian chlamydiosis and psittacosis. Virulence 15, 2428411. doi: 10.1080/21505594.2024.2428411
Wu, H. H., Feng, L. F., and Fang, S. Y. (2021). Application of metagenomic next-generation sequencing in the diagnosis of severe pneumonia caused by Chlamydia psittaci. BMC Pulm Med. 21, 300. doi: 10.1186/s12890-021-01673-6
Yap, J., Tay, W. T., Teng, T. K., Anand, I., Richards, A. M., Ling, L. H., et al. (2019). Association of diabetes mellitus on cardiac remodeling, quality of life, and clinical outcomes in heart failure with reduced and preserved ejection fraction. J. Am. Heart Assoc. 8, e013114. doi: 10.1161/jaha.119.013114
Yin, Y. and Wunderink, R. G. (2018). MERS, SARS and other coronaviruses as causes of pneumonia. Respirology 23, 130–137. doi: 10.1111/resp.13196
Zhang, F., Li, S., Yang, J., Yang, L., and He, C. (2009). Induction of a protective immune response against swine Chlamydophila abortus infection in mice following co-vaccination of omp-1 DNA with recombinant MOMP. Zoonoses Public Health 56, 71–76. doi: 10.1111/j.1863-2378.2008.01160.x
Zhang, Z., Zhou, H., Cao, H., Ji, J., Zhang, R., Li, W., et al. (2022). Human-to-human transmission of Chlamydia psittaci in China 2020: an epidemiological and aetiological investigation. Lancet Microbe 3, e512–e520. doi: 10.1016/s2666-5247(22)00064-7
Keywords: Chlamydia psittaci, Enterococcus faecalis, respiratory distress, coinfection, patient
Citation: Zhang X, Wang Y, Wang Y, Cui Y, Wang H, Huang Z, Luo L, Tang L, Chen J and He C (2025) Coinfection of Chlamydia psittaci and Enterococcus faecalis exacerbated respiratory distress in patients: from isolation to mouse model. Front. Cell. Infect. Microbiol. 15:1662902. doi: 10.3389/fcimb.2025.1662902
Received: 09 July 2025; Accepted: 22 September 2025;
Published: 10 October 2025.
Edited by:
Mohamed A. Abouelkhair, Rowan University, United StatesReviewed by:
Lihua Song, Beijing University of Chemical Technology, ChinaChuan Wang, University of South China, China
Copyright © 2025 Zhang, Wang, Wang, Cui, Wang, Huang, Luo, Tang, Chen and He. This is an open-access article distributed under the terms of the Creative Commons Attribution License (CC BY). The use, distribution or reproduction in other forums is permitted, provided the original author(s) and the copyright owner(s) are credited and that the original publication in this journal is cited, in accordance with accepted academic practice. No use, distribution or reproduction is permitted which does not comply with these terms.
*Correspondence: Cheng He, aGVjaGVuZ0BjYXUuZWR1LmNu
†These authors have contributed equally to this work